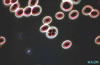

| Saccharomyces |

Saccharomyces |

Saccharomyces |
| S maya türüdür.Yaygın bir maya türüdür. Cinsin tipik türü S. cerevisiae 'dır. Bunlar bira mayalarıdırlar. |
| Saccharomyces |
Saccharomyces |

Saccharomyces |
| S maya türüdür.Yaygın bir maya türüdür. Cinsin tipik türü S. cerevisiae 'dır. Bunlar bira mayalarıdırlar. |